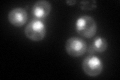
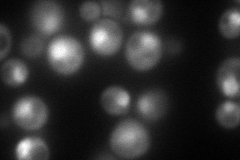
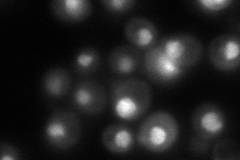
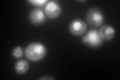
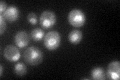

View description
Subunit of the 26S proteasome, substrate of the N-acetyltransferase Nat1p
Localization:
Intensity:
Fold change:
Significance:
-
C’ GFP library in SD
nucleus119.43 -
N' NOP1pr-GFP in SD
cytosol,nucleus174.657 -
N' TEF2pr-mCherry in SD

cytosol,nucleus6.38175 -
N' NATIVEpr-GFP in SD
nucleus112.718 -
N' TEF2pr-VC and Cyto-VN in SD

nucleus39.5869 -
C’ GFP library in SD+DTT
nucleus119.441No -
C’ GFP library in SD+H2O2

nucleus140.721.17No -
C’ GFP library in Starvation Media
nucleus81.360.68No -
C’ GFP library on the background of Pup2-DaMP

nucleus -
C’ GFP library on the background of CCT mutant

nucleus144.0821.20631No
